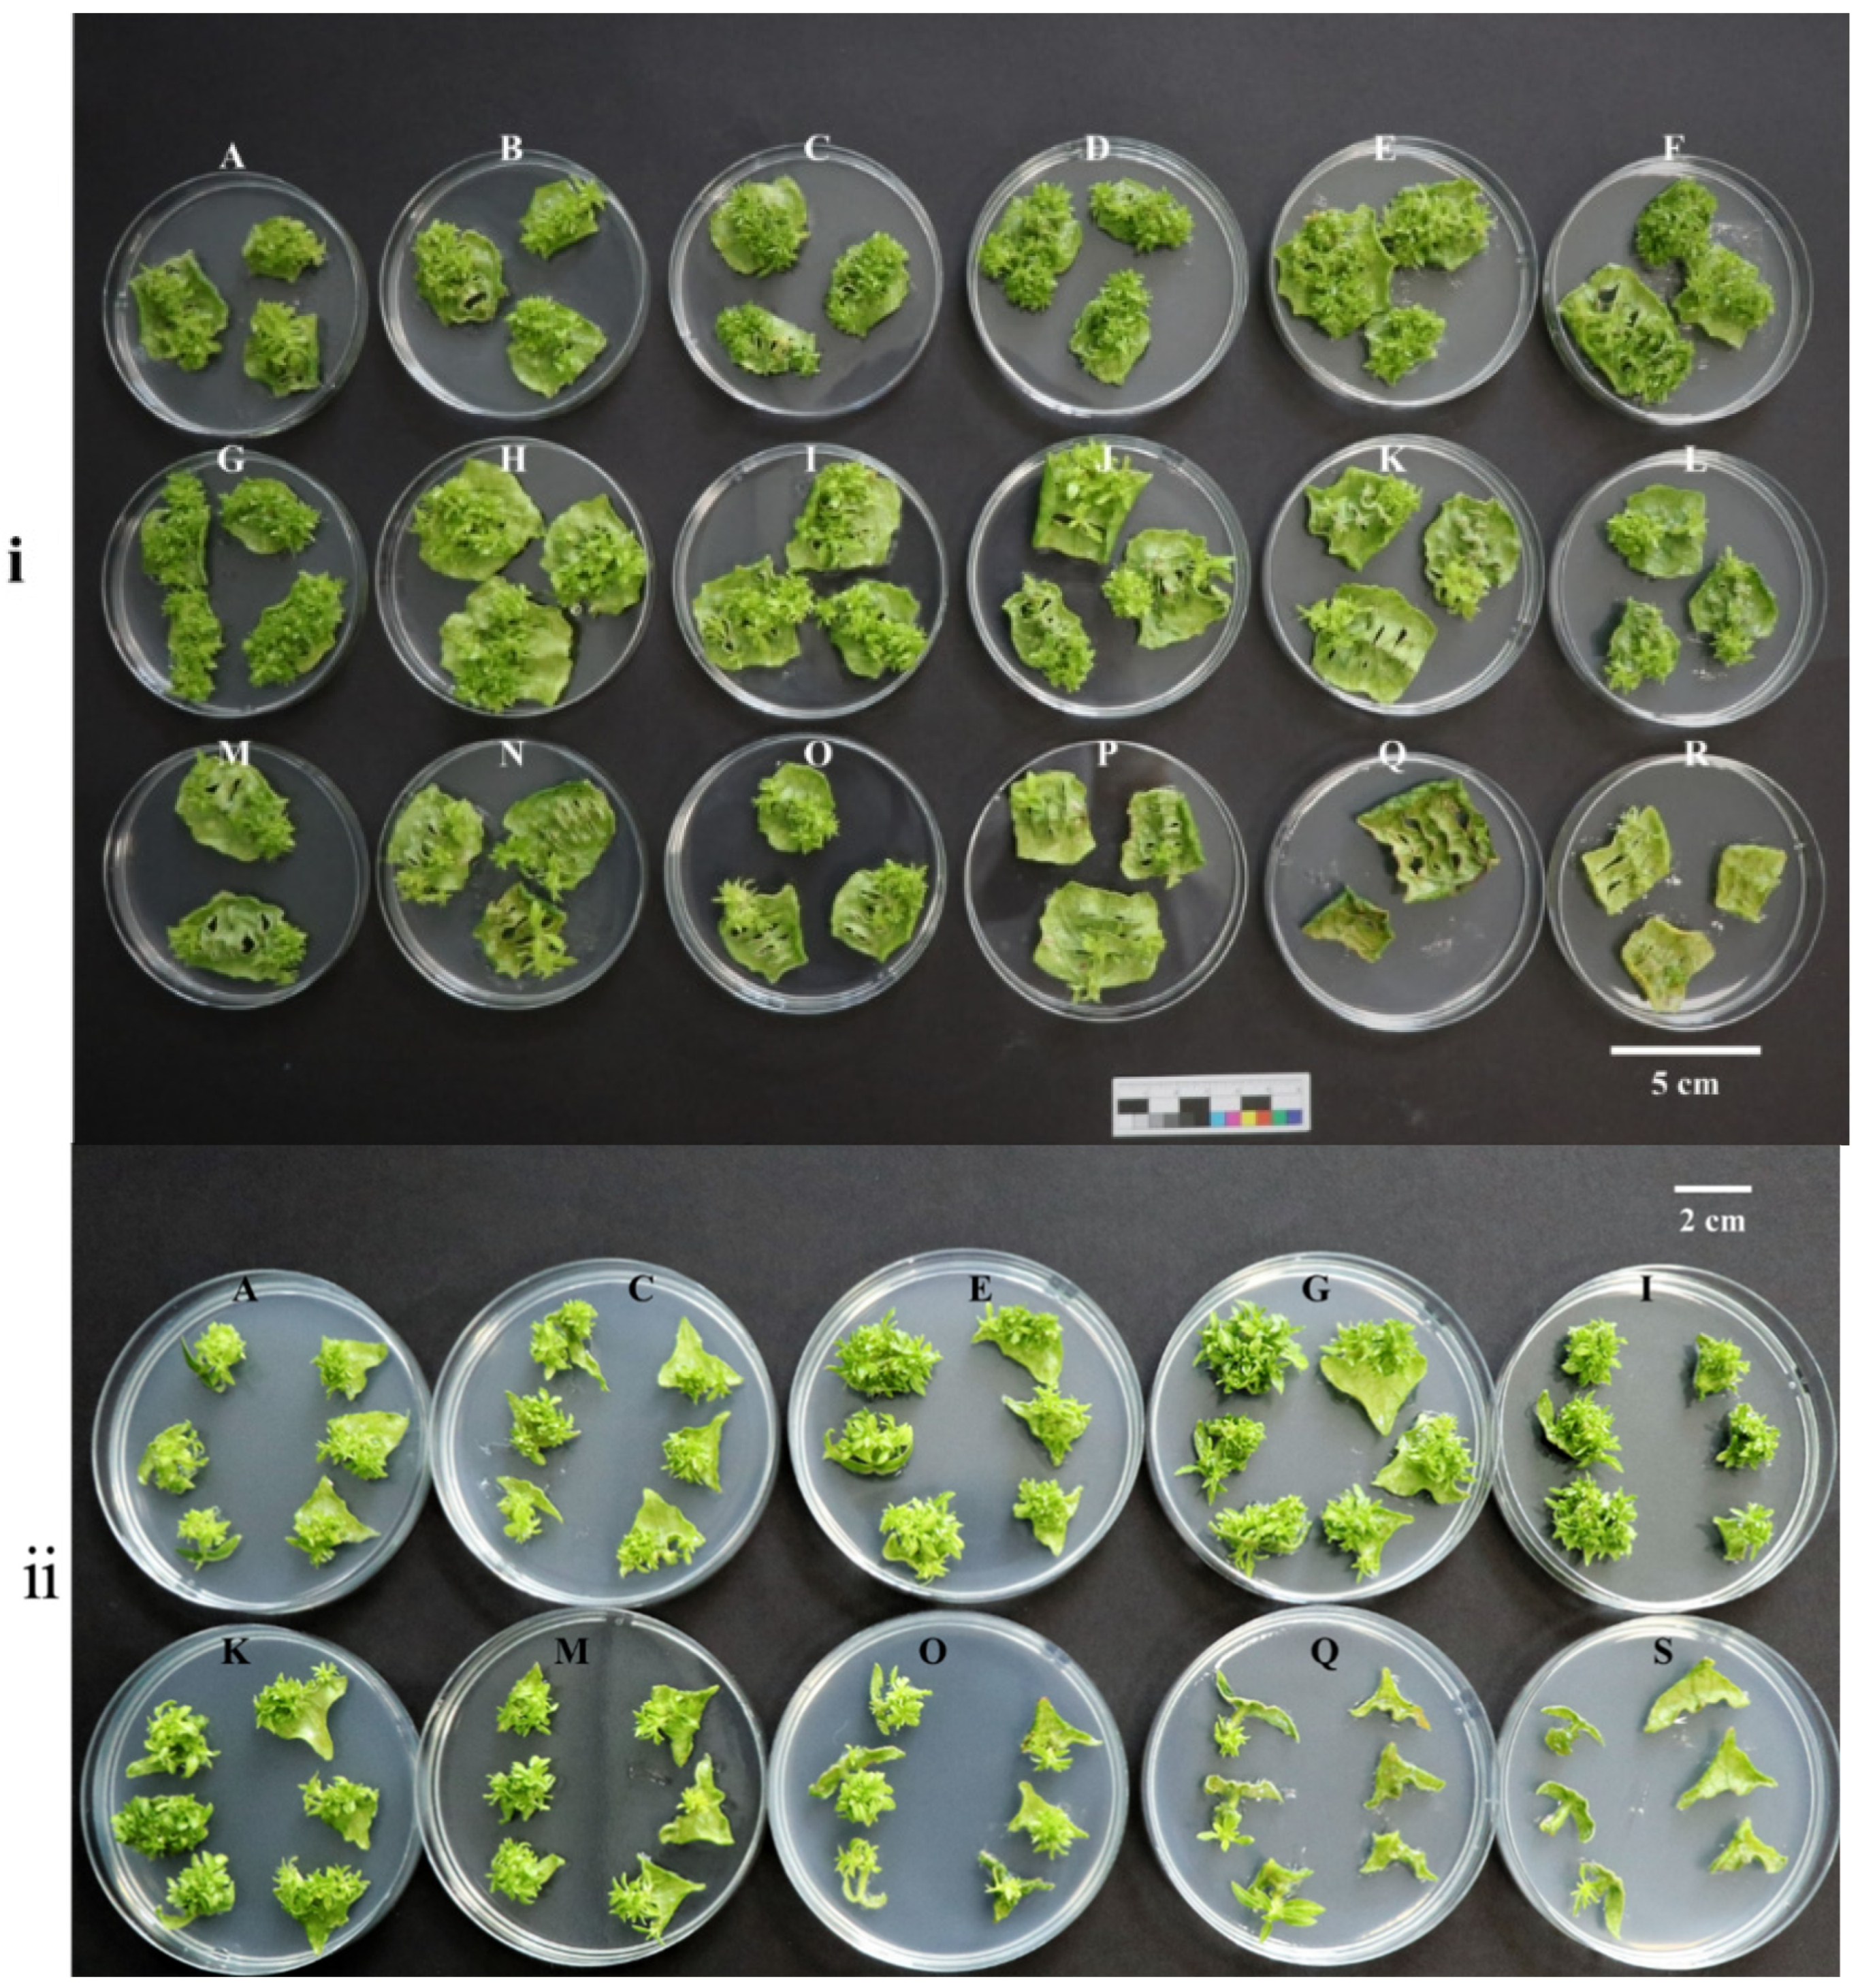
Forests 15 01474 g005

Construction of a Genetic Transformation System for Populus wulianensis
Abstract
1. Introduction
2. Materials and Methods
2.1. Source of Materials
2.1.1. Plant Materials of P. wulianensis
2.1.2. Strain and Plasmid
2.2. Methods
2.2.1. Leaf Adventitious Bud Induction
2.2.2. Antibiotic and Bacteriostatic Agent Concentration Screening Experiment
2.2.3. Genetic Transformation of P. wulianensis Leaf Discs
2.2.4. Evaluation of Transformation Factors on Genetic Efficiency
2.2.5. PCR and RT-PCR Analyses
2.2.6. Observation of EGFP Expression
2.2.7. Statistical Analysis
3. Results
3.1. Effects of Medium Components on the Induction of Adventitious Buds of P. wulianensis Leaves
3.2. Screening of Critical Antibiotic Concentrations
3.2.1. Determination of Critical Screening Pressure for Timentin
3.2.2. Determination of Kan Critical Screening Pressure
3.3. Optimization of a Genetic Transformation System for P. wulianensis
3.4. Verification of a Genetic Transformation System for P. wulianensis
4. Discussion
4.1. Comparison of Adventitious Bud Regeneration System of Poplar
4.2. Comparison of Poplar Genetic Transformation Systems
4.3. Analysis of Factors Affecting Conversion Efficiency
4.4. False Positive Exclusion Analysis
5. Conclusions
Supplementary Materials
Author Contributions
Funding
Data Availability Statement
Conflicts of Interest
Abbreviations
| MS | Murashige and Skoog medium |
| NAA | Naphthalene acetic acid |
| 6-BA | 6-Benzylaminopurine |
| EGFP | Enhanced green fluorescent protein |
| DAPI | 4′,6-Diamidino-2-phenylindole |
| PCR | Polymerase chain reaction |
| β-AS | Acetylsyringone |
| WT | Wild type |
References
- Franklin, O.; Palmroth, S.; Näsholm, T. How eco-evolutionary principles can guide tree breeding and tree biotechnology for enhanced productivity. Tree Physiol. 2014, 34, 1149–1166. [Google Scholar] [CrossRef] [PubMed]
- Wang, H.; Wang, C.; Liu, H.; Tang, R.; Zhang, H. An efficient Agrobacterium-mediated transformation and regeneration system for leaf explants of two elite aspen hybrid clones Populus alba × P. berolinensis and Populus davidiana × P. bolleana. Plant Cell Rep. 2011, 30, 2037–2044. [Google Scholar] [CrossRef]
- Flachowsky, H.; Hanke, M.V.; Peil, A.; Strauss, S.H.; Fladung, M. A review on transgenic approaches to accelerate breeding of woody plants. Plant Breed. 2009, 128, 217–226. [Google Scholar] [CrossRef]
- Han, X.; Ma, S.; Kong, X.; Takano, T.; Liu, S. Efficient Agrobacterium-Mediated Transformation of Hybrid Poplar Populus davidiana Dode × Populus bollena Lauche. Int. J. Mol. Sci. 2013, 14, 2515–2528. [Google Scholar] [CrossRef] [PubMed]
- John, E.; Maqbool, A.; Malik, K. Optimization of Agrobacterium tumefaciens mediated transformation in Populus deltoids. Pak. J. Bot. 2014, 46, 1079–1086. [Google Scholar]
- Parsons, T.J.; Sinkar, V.P.; Stettler, R.F.; Nester, E.W.; Gordon, M.P. Transformation of Poplar by Agrobacterium tumefaciens. Nat. Biotechnol. 1986, 4, 533–536. [Google Scholar] [CrossRef]
- Yin, D.M. A review of the genomic and gene cloning studies in trees. Hereditas 2010, 32, 677–684. [Google Scholar] [CrossRef]
- Chen, Y.N.; Hu, C.J.; Zu, G.Q.; Hu, J.J.; Yin, D.M. Thirty Years of Agrobacterium-Mediated Genetic Transformation of Populus. Sci. Silvae Sin. 2022, 58, 114–129. [Google Scholar]
- Ding, L.P.; Wang, H.Z.; Wei, J.H. Progress and Prospect of Research in Transgenic Poplar. For. Res. 2016, 29, 124–132. [Google Scholar]
- Niedbała, G.; Niazian, M.; Sabbatini, P. Modeling Agrobacterium-Mediated Gene Transformation of Tobacco (Nicotiana tabacum)—A Model Plant for Gene Transformation Studies. Front. Plant Sci. 2021, 12, 695110. [Google Scholar] [CrossRef]
- Movahedi, A.; Zhang, J.; Amirian, R.; Zhuge, Q. An Efficient Agrobacterium-Mediated Transformation System for Poplar. Int. J. Mol. Sci. 2014, 15, 10780–10793. [Google Scholar] [CrossRef]
- Yevtushenko, D.P.; Misra, S. Efficient Agrobacterium-mediated transformation of commercial hybrid poplar Populus nigra L. × P. maximowiczii A. Henry. Plant Cell Rep. 2010, 29, 211–221. [Google Scholar] [CrossRef] [PubMed]
- Yu, Z.C.; Ling, C.; Chen, Y.N.; Li, S.X.; Yin, D.M.; Li, X.P. Establishment of regeneration system and study on genetic transformation for male diploid Populus tomentosa. J. Nanjing For. Univ. (Nat. Sci. Ed.) 2022, 46, 187–196. [Google Scholar]
- Wen, S.S.; Ge, X.L.; Wang, R.; Yang, H.F.; Bai, Y.E.; Guo, Y.H.; Zhang, J.; Lu, M.Z.; Zhao, S.T.; Wang, L.Q. An efficient Agrobacterium-mediated transformation method for hybrid Poplar 84K (Populus alba × P. glandulosa) using Calli as explants. Int. J. Mol. Sci. 2022, 23, 2216. [Google Scholar] [CrossRef]
- Ma, J.; Wan, D.; Duan, B.; Bai, X.; Bai, Q.; Chen, N.; Ma, T. Genome sequence and genetic transformation of a widely distributed and cultivated poplar. Plant Biotechnol. J. 2019, 17, 451–460. [Google Scholar] [CrossRef]
- Liang, S.B.; Li, X.W. A new species of populus from Shandong. Bull. Bot. Res. 1986, 6, 135–137. [Google Scholar]
- Wu, Q.; Zang, F.; Xie, X.; Ma, Y.; Zheng, Y.; Zang, D. Full-length transcriptome sequencing analysis and development of EST-SSR markers for the endangered species Populus wulianensis. Sci. Rep. 2020, 10, 16249. [Google Scholar] [CrossRef]
- Wu, Q.; Zang, F.; Ma, Y.; Zheng, Y.; Zang, D. Analysis of genetic diversity and population structure in endangered Populus wulianensis based on 18 newly developed EST-SSR markers. Glob. Ecol. Conserv. 2020, 24, e01329. [Google Scholar] [CrossRef]
- Wang, Y.; Wu, D.; Liu, L.J.; Han, Y.; Sun, T.; Wang, N.; Xie, X.M.; Dong, X.; Lu, Y.Z. Establishment of generation system for Populus wulianensis and control of vitrification of its test-tube seedlings. Mol. Plant Breed. 2019, 17, 6434–6446. [Google Scholar] [CrossRef]
- Jia, T.; Tang, T.; Cheng, B.C.; Zhou, L.; Peng, Y. Development of two protocols for Agrobacterium-mediated transformation of white clover (Trifolium repens) via the callus system. 3 Biotech 2023, 13, 150. [Google Scholar] [CrossRef]
- Porebski, S.; Bailey, L.G.; Baum, B.R. Modification of a CTAB DNA extraction protocol for plants containing high polysaccharide and polyphenol components. Plant Mol. Biol. Rep. 1997, 15, 8–15. [Google Scholar] [CrossRef]
- Ma, C.; Strauss, S.H.; Meilan, R. Agrobacterium-mediated transformation of the genome-sequenced poplar clone, Nisqually-1 (Populus trichocarpa). Plant Mol. Biol. Rep. 2004, 22, 311a. [Google Scholar] [CrossRef]
- Giri, C.C.; Shyamkumar, B.; Anjaneyulu, C. Progress in tissue culture, genetic transformation and applications of biotechnology to trees: An overview. Trees 2004, 18, 115–135. [Google Scholar] [CrossRef]
- Song, C.; Lu, L.; Guo, Y.; Xu, H.; Li, R. Efficient Agrobacterium-Mediated Transformation of the Commercial Hybrid Poplar Populus Alba × Populus glandulosa Uyeki. Int. J. Mol. Sci. 2019, 20, 2594. [Google Scholar] [CrossRef]
- Li, S.J.; Zhen, C.; Xu, W.J.; Wang, C.; Cheng, Y.X. Simple, rapid and efficient transformation of genotype Nisqually-1: A basic tool for the first sequenced model tree. Sci. Rep. 2017, 7, 2638. [Google Scholar] [CrossRef]
- Zhan, X.C.; Kawai, S.; Katayama, Y.; Morohoshi, N. A new approach based on the leaf disc method for Agrobacterium mediated transformation and regeneration of aspen. Plant Sci. 1997, 123, 105–112. [Google Scholar] [CrossRef]
- Li, C.L.; Wang, X.J.; Ding, Q.Q.; Wu, H. Optimization of leaf regeneration and genetic transformation system of Populus tomentosa. Bull. Bot. Res. 2016, 36, 177–183. [Google Scholar]
- Huang, D.; Dai, W. Direct regeneration from in vitro leaf and petiole tissues of Populus tremula ‘Erecta’. Plant Cell Tissue Organ Cult. (PCTOC) 2011, 107, 169–174. [Google Scholar] [CrossRef]
- Li, J.H.; Xing, S.Y.; Jiao, Z.; Liu, X.G.; Zhang, Y.P. Tissue culture and regeneration system from leaves of Populus leucopyramidalis in vitro. Chin. Agric. Sci. Bull. 2008, 24, 60–64. [Google Scholar]
- Wang, B.; Ling, B.L.; Zhang, J.F.; Hong, X.L.; Mu, C.L. Establishment of in vitro regeneration system of Poplar Hybrid 717 and 353. Acta Bot. Boreali-Occident. Sin. 2009, 29, 704–710. [Google Scholar]
- Huang, S.; Gao, K.; Miao, D.Y.; An, X.M. Establishment of regeneration and genetic transformation system of elite clone GM107 of Populus tomentosa. Mol. Plant Breed. 2022, 21, 1–22. [Google Scholar]
- Li, K.Y.; Fan, J.F.; Zhao, Z.; Zhou, Y.X.; Gao, J.S. Prioritization of the system of regeneration and genetic transformation of Populus 84K. J. Northwest A F Univ. (Nat. Sci. Ed.) 2007, 35, 90–96. [Google Scholar]
- Zhang, Y.; Fan, J.F.; Gao, J.S.; Zhou, Y.X. Establishment of an efficient regeneration system for the Populus adenopoda × the poplar 84K. North. Hortic. 2010, 9, 152–156. [Google Scholar]
- Wang, H.L. Establishment of efficient tissue culture regeneration system of Populus. North. Hortic. 2010, 13, 174–175. [Google Scholar]
- Wu, R.H.; Dai, J.L.; Bai, X.D.; Bai, Y.E. Establishment of the regeneration system of Populus hopeiensis leaf induced adventitious buds. J. Inn. Mong. Agric. Univ. (Nat. Sci. Ed.) 2021, 42, 34–38. [Google Scholar]
- Long, C.; Pang, X.M.; Cao, G.L.; Liu, Y.; Zhang, Z.Y. A study on the efficient protocol for transforming MdSPDS1 gene into Populus tomentosa Carr. J. Beijing For. Univ. 2010, 32, 21–26. [Google Scholar]
- Hu, L.; Lu, H.; Liu, Q.; Chen, X.; Jiang, X. Overexpression of mtlD gene in transgenic Populus tomentosa improves salt tolerance through accumulation of mannitol. Tree Physiol. 2005, 25, 1273–1281. [Google Scholar] [CrossRef]
- Zhang, B.Y.; Su, X.H.; Zheng, S.X. Establishment of a highly efficient plant regeneration system of Populus davidiana × P. bolleana and study of its genetic stability. J. Beijing For. Univ. 2008, 30, 68–73. [Google Scholar]
- Tsai, C.J.; Podila, G.K.; Chiang, V.L. Agrobacterium-mediated transformation of quaking aspen (Populus tremuloides) and regeneration of transgenic plants. Plant Cell Rep. 1994, 14, 94–97. [Google Scholar] [CrossRef]
- Zhang, B.Y.; Su, X.H.; Huang, Q.J.; Zhang, X.H.; Hu, Z.M. Regeneration of transgenic Poplar (Populus alba × P. glandulosa) expressing levansucrase from Bacillus subtilis. Sci. Silvae Sin. 2005, 41, 48–53. [Google Scholar]
- Dai, W.; Cheng, Z.-M.; Sargent, W. Plant regeneration and Agrobacterium-mediated transformation of two elite aspen hybrid clones from in vitro leaf tissues. Vitr. Cell. Dev. Biol.-Plant 2003, 39, 6–11. [Google Scholar] [CrossRef]
- Busov, V.B.; Brunner, A.M.; Meilan, R.; Filichkin, S.; Ganio, L.; Gandhi, S.; Strauss, S.H. Genetic transformation: A powerful tool for dissection of adaptive traits in trees. New Phytol. 2005, 167, 9–18. [Google Scholar] [CrossRef] [PubMed]
- Hu, J.; Wang, L.; Yan, D.; Lu, M.Z. Research and Application of Transgenic Poplar in China. In Challenges and Opportunities for the World’s Forests in the 21st Century; Fenning, T., Ed.; Springer: Dordrecht, The Netherlands, 2014; pp. 567–584. [Google Scholar]
- Rajesh, M.; Jeyaraj, M.; Sivanandhan, G.; Subramanyam, K.; Mariashibu, T.S.; Mayavan, S.; Kapil Dev, G.; Anbazhagan, V.R.; Manickavasagam, M.; Ganapathi, A. Agrobacterium-mediated transformation of the medicinal plant Podophyllum hexandrum Royle (syn. P. emodi Wall. ex Hook.f. & Thomas). Plant Cell Tissue Organ Cult. (PCTOC) 2013, 114, 71–82. [Google Scholar] [CrossRef]
- Yang, Y.P.; Li, Y.L.; Lu, J.L.; Zheng, X.Q. Antibiotics inhibition to Agrobaceterium rhizogenes and effect to tea multiple shoots. J. Tea Sci. 2015, 35, 437–442. [Google Scholar] [CrossRef]
- Nauerby, B.; Billing, K.; Wyndaele, R. Influence of the antibiotic timentin on plant regeneration compared to carbenicillin and cefotaxime in concentrations suitable for elimination of Agrobacterium tumefaciens. Plant Sci. 1997, 123, 169–177. [Google Scholar] [CrossRef]
- Stevens, M.E.; Pijut, P.M. Agrobacterium-mediated genetic transformation and plant regeneration of the hardwood tree species Fraxinus profunda. Plant Cell Rep. 2014, 33, 861–870. [Google Scholar] [CrossRef]
- Naing, A.H.; Kim, C.K.; Yun, B.J.; Jin, J.Y.; Lim, K.B. Primary and secondary somatic embryogenesis in Chrysanthemum cv. Euro. Plant Cell Tissue Organ Cult. (PCTOC) 2013, 112, 361–368. [Google Scholar] [CrossRef]
- Lin, J.J.; Assad-Garcia, N.; Kuo, J. Plant hormone effect of antibiotics on the transformation efficiency of plant tissues by Agrobacterium tumefaciens cells. Plant Sci. 1995, 109, 171–177. [Google Scholar] [CrossRef]
- Li, B.; Xie, C.; Qiu, H. Production of selectable marker-free transgenic tobacco plants using a non-selection approach: Chimerism or escape, transgene inheritance, and efficiency. Plant Cell Rep. 2009, 28, 373–386. [Google Scholar] [CrossRef]
- Cervera, M.; Pina, J.A.; Juárez, J.; Navarro, L.; Peña, L. A broad exploration of a transgenic population of citrus: Stability of gene expression and phenotype. Theor. Appl. Genet. 2000, 100, 670–677. [Google Scholar] [CrossRef]
- Akiyoshi, D.E.; Regier, D.A.; Jen, G.; Gordon, M.P. Cloning and nucleotide sequence of the tzs gene from Agrobacterium tumefaciens strain T37. Nucleic Acids Res. 1985, 13, 2773–2788. [Google Scholar] [CrossRef] [PubMed]
- Wang, Y.; Li, M.T.; Mu, Y.J.; Guan, L.S.; Wu, F.S.; Liu, K.; Li, M.; Wang, N.; Zhuang, Z.J.; Zhao, Y.C.; et al. PwuWRKY48 Confers Drought Tolerance in Populus wulianensis. Forests 2024, 15, 302. [Google Scholar] [CrossRef]

| Level | Basal Medium (A) | NAA (mg/L) (B) | 6-BA (mg/L) (C) | Dark Culture Time (d) (D) |
|---|---|---|---|---|
| 1 | (1/2NH4NO3) MS | 0.01 | 0.1 | 0 |
| 2 | 1/2MS | 0.05 | 0.5 | 4 |
| 3 | MS | 0.10 | 1.0 | 8 |
| Code | A | B | C | D | Average Number of Regenerated Buds |
|---|---|---|---|---|---|
| 1 | 3(MS) | 2 (0.05) | 3 (1.0) | 1 (0 d) | 1.67 ± 0.72 e |
| 2 | 3(MS) | 3 (0.10) | 1 (0.1) | 2 (4 d) | 17.33 ± 1.70 c |
| 3 | 2(1/2MS) | 1 (0.01) | 3 (1.0) | 2 (4 d) | 10.00 ± 0.82 d |
| 4 | 2(1/2MS) | 3 (0.10) | 2 (0.5) | 1 (0 d) | 3.33 ± 2.05 e |
| 5 | 2(1/2MS) | 2 (0.05) | 1 (0.1) | 3 (8 d) | 15.00 ± 3.27 c |
| 6 | 1(1/2(NH4NO3) MS) | 3 (0.10) | 3 (1.0) | 3 (8 d) | 22.33 ± 2.05 b |
| 7 | 1(1/2(NH4NO3) MS) | 1 (0.01) | 1 (0.1) | 1 (0 d) | 19.00 ± 2.94 c |
| 8 | 3(MS) | 1 (0.01) | 2 (0.5) | 3 (8 d) | 17.67 ± 1.70 c |
| 9 | 1(1/2(NH4NO3) MS) | 2 (0.05) | 2 (0.5) | 2 (4 d) | 34.67 ± 3.30 a |
| Code | Concentration mg/L | Middle of the Leaf | Top of the Leaf | Bottom of the Leaf |
|---|---|---|---|---|
| A | 0 | 32.30 ± 1.15 cd | 16.00 ± 0.66 bc | 14.70 ± 0.18 e |
| B | 50 | 37.70 ± 0.35 bc | / | / |
| C | 100 | 39.30 ± 0.98 bc | 17.70 ± 0.98 bc | 15.30 ± 1.12 e |
| D | 150 | 41.30 ± 1.52 ab | / | / |
| E | 200 | 42.30 ± 1.34 ab | 20.001.25 ab | 24.00 ± 1.75 cd |
| F | 250 | 49.30 ± 0.33 a | / | / |
| G | 300 | 50.30 ± 1.71 a | 24.30 ± 1.26 a | 35.70 ± 1.27 b |
| H | 350 | 40.00 ± 1.11 bc | / | / |
| I | 400 | 34.00 ± 0.68 bc | 20.70 ± 1.31 ab | 44.00 ± 2.05 a |
| J | 450 | 27.30 ± 1.28 d | / | / |
| K | 500 | 16.00 ± 0.53 e | 13.00 ± 1.09 cd | 26.00 ±1.02 c |
| L | 550 | 14.70 ± 1.14 e | / | / |
| M | 600 | 11.70 ± 0.39 ef | 7.70 ± 0.88 d | 17.00 ± 0.72 de |
| N | 650 | 8.00 ± 0.27 ef | / | / |
| O | 700 | 7.70 ± 1.02 ef | 5.70 ± 0.42 e | 12.70 ± 0.93 e |
| P | 750 | 7.00 ± 0.83 ef | / | / |
| Q | 800 | 2.70 ± 0.57 f | 0.00 ± 0.00 | 3.70 ± 0.14 f |
| R | 850 | 1.70 ± 0.24 f | / | / |
| S | 900 | / | 0.00 ± 0.00 | 1.70 ± 0.70 f |
| Kan Concentration(mg/L) | Indeterminate Number of Buds | Leaf-Induced Growth Status | Rooting Rate (%) | Adventitious Buds Induce Rooting |
|---|---|---|---|---|
| 0 | 33.30 ± 1.28 a | All three parts of the leaf blade were dark green and had the highest number of differentiated buds. | 100.00 | All rooted, green plants, healthy growth. |
| 25 | 15.70 ± 1.09 b | All three parts of the leaf blade were green, and 50% of the B part of the leaf produced adventitious buds. | 50.00 | Half rooted, and the other leaves were light green. |
| 50 | 5.00 ± 0.27 c | Leaf A was slightly yellow; the rest was green, and 30% of leaf B produced adventitious buds. | 42.67 | Some were rooted, whereas others were yellowed. |
| 75 | 3.70 ± 0.33 c | Only the C part of the leaf produced adventitious buds, whereas the other parts of the leaf did not produce adventitious buds. | 23.08 | A small part of the leaves took root, and a small part of the leaves appeared vitrified. |
| 100 | 2.00 ± 0.18 c | Only a small part of the leaf C part produced adventitious buds, and the leaf B part appeared yellow. | 0.00 | The base was swollen; none of them took root, and the adventitious buds grew slowly. |
| 125 | 1.70 ± 0.15 c | Very few leaves had adventitious bud differentiation in the leaf C part, and no adventitious buds were produced in the others. | 0.00 | A few had swollen bases; none of them took root, and adventitious buds had stagnated growth. |
| 150 | 0.00 ± 0.00 | Dehydration began to appear in all three parts of the leaves, and there was no redifferentiation or adventitious buds. | 0.00 | The base was not enlarged and did not take root, and the adventitious bud leaves were partially yellowed. |
| 175 | 0.00 ± 0.00 | The three parts of the leaf showed different degrees of whitening, with no redifferentiation or adventitious buds. | 0.00 | The base was not swollen and did not take root, and the adventitious bud leaves were curled and yellowed. |
| 200 | 0.00 ± 0.00 | The three parts of the leaves were dehydrated and whitish, and there were no adventitious buds. | 0.00 | The base was not swollen and did not take root, and the leaves of adventitious buds were partially dry. |
| OD600 | Number of Resistant Buds | Growth State |
|---|---|---|
| 0.60 | 1.44 ± 0.51 b | The leaves gradually turned pale green and eventually withered, often displaying white plaques. |
| 0.30 | 5.11 ± 0.92 a | A few leaf edges showed signs of fading with faintly visible colonies. |
| 0.15 | 3.89 ± 0.87 ab | Several leaves exhibited fading with faintly visible colonies. |
| Infection Time/min | Number of Resistant Buds | Growth State |
|---|---|---|
| 5 | 3.36 ± 0.45 b | Leaf disks remained green, with no colonies visible. |
| 15 | 6.38 ± 1.28 a | Leaf blade margins displayed reddish brown, whereas wounds exhibited multiple buds and pale mycorrhizae. |
| 20 | 2.92 ± 0.31 b | Leaf disks appeared dry with visible marginal mycorrhiza. |
| β-AS Concentration /μmol·L−1 | Number Of Resistant Buds | Growth State |
|---|---|---|
| 0 | 2.94 ± 0.73 b | Dry spots appeared with yellowing of the leaf margins. |
| 100 | 5.95 ± 1.12 a | Leaf disks remained green, with many buds forming around the wounds. |
| 200 | 6.45 ± 1.34 a | Brown spots developed, with more buds forming around the wound. |
| Co-Culture Time/d | Number of Resistant Buds | Growth State |
|---|---|---|
| 1 | 0.00 ± 0.00 c | Leaf disks appeared greenish but dry without any visible adventitious buds. |
| 3 | 6.11 ± 1.43 a | Yellowing was observed along the margins of the leaf disks, with green adventitious buds but no visible mycorrhizae. |
| 6 | 2.95 ± 0.22 b | Late leaf discs appeared dry and exhibited white fungal spots. |
| Populus Species/Hybrid | Explants | Adventitious Buds | Reference |
|---|---|---|---|
| P. tomentosa (clone GM107) | Leaf | 20.00 | Huang et al., 2023 [31] |
| P. alba × P. glandulosa | Leaf | 20.00 | Li et al., 2007 [32] |
| P. adenopoda × poplar84K | Leaf | 14.80 | Zhang et al., 2010 [33] |
| P. dabidiana × P. bolleana | Leaf | 12.10 | Wang et al., 2010 [34] |
| P. hopeiensis | Leaf | 11.40 | Wu et al., 2021 [35] |
| P. tremuloides | Leaf | 10.00 | Huang et al., 2011 [28] |
| P. Leucopyramidalis | Leaf | 8.20 | Li et al., 2008 [32] |
| P. tomentosa (male diploid) | Leaf | 6.63 | Yu et al., 2022 [13] |
| P. tremula × P. alba | Leaf | 4.27 | Wang et al., 2009 [30] |
| P. tomentosa | Leaf | 3.40 | Li et al., 2016 [27] |
| P. tremula × P. tremuloides | Leaf | 2.73 | Wang et al., 2009 [30] |
| Populus Species/Hybrid | Positive Rate | Selective Agent and Its Concentration(mg/L) | Bacterial Inhibitor and Its Concentration (mg/L) | Reference |
|---|---|---|---|---|
| P. dabidiana × P. bolleana | 9.30% | 25–50, Kan | 500, Cef | Wang et al., 2011 [2] |
| P. tomentosa | 9.38% | 20–50, Kan | 150–250, Cef | Long et al., 2010 [36] |
| Male diploid P. tomentosa | 16.28% | 30, Kan | 200 Cef + 200 timentin | Yu et al., 2022 [13] |
| P. alba var. pyramidalis | 23.60% | 90, Hygromycin | 400, Cef | Ma et al., 2019 [15] |
| P. dabidiana × P. bolleana | 30.00% | 50, Kan | Unmarked | Han et al., 2013 [4] |
| P. tomentosa | 36.32% | 30–50, Kan | 300, Cef | Hu et al., 2005 [37] |
| P. alba × P. glandulosa cv. 84K | 51.54% | 50–60, Kan | 300, Cef | Zhang et al., 2005 [40] |
| P. dabidiana × P. bolleana | 93.33% | 30–60, Kan | Unmarked | Zang et al., 2008 [38] |
| P. canescens × P. grandidentata | 93.33% | 60–80, Kan | 250 Cef + 500 Car | Dai et al., 2003 [41] |
| P. tremuloides (clone 271) | 94.17% | 40–100, Kan | 300, Cef | Tsai et al., 1994 [39] |
Disclaimer/Publisher’s Note: The statements, opinions and data contained in all publications are solely those of the individual author(s) and contributor(s) and not of MDPI and/or the editor(s). MDPI and/or the editor(s) disclaim responsibility for any injury to people or property resulting from any ideas, methods, instructions or products referred to in the content. |
© 2024 by the authors. Licensee MDPI, Basel, Switzerland. This article is an open access article distributed under the terms and conditions of the Creative Commons Attribution (CC BY) license (https://creativecommons.org/licenses/by/4.0/).
Share and Cite
Wang, Y.; Song, C.; Han, Y.; Wang, R.; Guan, L.; Mu, Y.; Sun, T.; Xie, X.; Zhao, Y.; Xu, J.; et al. Construction of a Genetic Transformation System for Populus wulianensis. Forests 2024, 15, 1474. https://doi.org/10.3390/f15081474
Wang Y, Song C, Han Y, Wang R, Guan L, Mu Y, Sun T, Xie X, Zhao Y, Xu J, et al. Construction of a Genetic Transformation System for Populus wulianensis. Forests. 2024; 15(8):1474. https://doi.org/10.3390/f15081474
Chicago/Turabian StyleWang, Yan, Chenxia Song, Yi Han, Ruilong Wang, Lingshan Guan, Yanjuan Mu, Tao Sun, Xiaoman Xie, Yunchao Zhao, Jichen Xu, and et al. 2024. "Construction of a Genetic Transformation System for Populus wulianensis" Forests 15, no. 8: 1474. https://doi.org/10.3390/f15081474
APA StyleWang, Y., Song, C., Han, Y., Wang, R., Guan, L., Mu, Y., Sun, T., Xie, X., Zhao, Y., Xu, J., & Lu, Y. (2024). Construction of a Genetic Transformation System for Populus wulianensis. Forests, 15(8), 1474. https://doi.org/10.3390/f15081474

